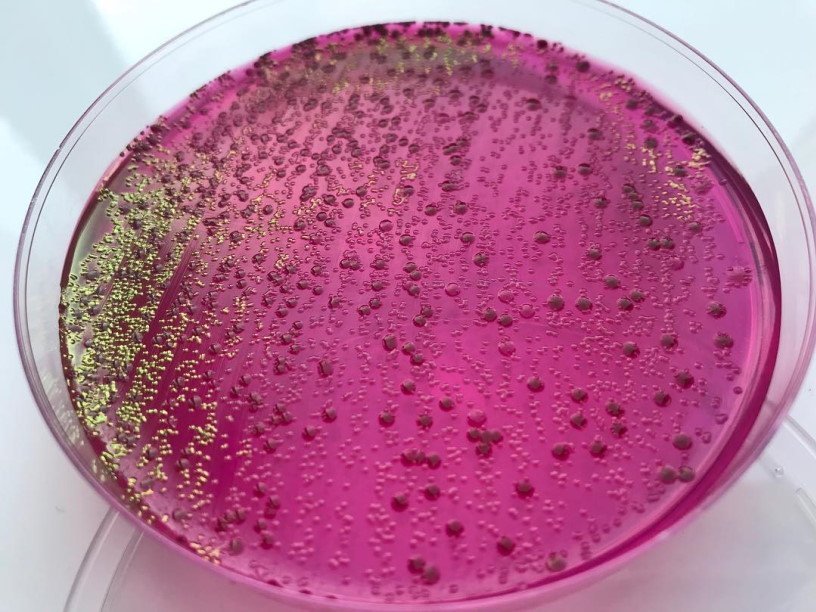

Екатерина Беленко: Промикробы: Маленькие помощники пищеварения
Бифидобактерии — род грамположительных анаэробных бактерий, представляющих собой слегка изогнутые палочки (длиной 2–5 мкм), иногда ветвящиеся на концах, спор они не образуют. Название «бифидобактерии» происходит от латинского корня, означающего «разделенный надвое». Впервые бифидобактерии описал Тисьер примерно в 1900 году. Он выделил из фекалий вскормленного грудью младенца культуру анаэробных бактерий, клетки которых обладали специфической Y-образной морфологией. Но на самом деле они не всегда такой формы, бифидобактерии обладают свойством плейоморфизма. Это способность некоторых микроорганизмов изменять свою морфологию, биологические функции или репродуктивный режим в ответ на условия окружающей среды. Прогибаются под изменчивый мир, чтобы выжить. И оказалось, что раздвоенная вилочкообразная форма, так удивившая исследователей и давшая микробикам название, на самом деле встречается на «бедных» питательных средах.
Бифидобактерии являются очень важными и полезными квартирантами нашего организма. Я не буду утверждать это голословно, а подкреплю фактами. Итак, бифидобактерии осуществляют путем ассоциации со слизистой оболочкой кишечника физиологическую защиту кишечного барьера от проникновения микробов и токсинов во внутреннюю среду организма. еще они обладают высокой антагонистической активностью по отношению к патогенным и условно патогенным микроорганизмам за счет выработки органических жирных кислот.
Кроме того, бифидобактерии участвуют в утилизации пищевых субстратов и активизации пристеночного пищеварения. Но и это еще не все! Они синтезируют аминокислоты и белки, витамин К, витамины группы В: B1 — тиамин, B2 — рибофлавин, B5 — пантотеновую кислоту, B3 — никотиновую кислоту, B6 — пиридоксин, В9 — фолиевую кислоту. А также способствуют усилению процессов всасывания через стенки кишечника ионов кальция, железа, витамина D. Впечатляет, правда?
Бифидобактерии относятся к группе молочнокислых бактерий, о которых мы активно говорим последние две недели. Но есть и некоторое отличие: их брожение является гетероферментативным. При гомоферментативном молочнокислом брожении сахара сбраживаются через гликолиз, и около 90 % конечного продукта приходится на лактат (остальные 10 % составляют ацетат, ацетоин и этанол). Основным субстратом для гомоферментативного молочнокислого брожения служит лактоза. А при гетероферментативном молочнокислом брожении сахара сбраживаются через пентозофосфатный путь, и на долю молочной кислоты приходится лишь около половины конечного продукта. Помимо лактата, при гетероферментативном брожении образуются ацетат, этанол и углекислый газ. Основным субстратом для гетероферментативного молочнокислого брожения является мальтоза.
Бифидобактерии в процессе жизнедеятельности вырабатывают не только молочную, а целый ряд органических кислот. Это, например, уксусная, муравьиная и янтарная. И эти продукты брожения, осуществляемого бифидобактериями, подавляют рост гнилостной микрофлоры. В настоящее время при дисбактериозе, вызванном, например, приемом антибиотиков, назначают пробиотики, содержащие молочнокислые бактерии. Теперь вы знаете чуть больше о невидимых героях вашего кишечника.